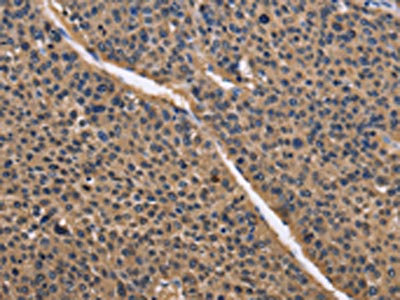

-
中文名稱:IDH1兔多克隆抗體
-
貨號:CSB-PA826954
-
規格:¥1100
-
圖片:
-
The image on the left is immunohistochemistry of paraffin-embedded Human liver cancer tissue using CSB-PA826954(IDH1 Antibody) at dilution 1/50, on the right is treated with fusion protein. (Original magnification: ×200)
-
The image on the left is immunohistochemistry of paraffin-embedded Human lung cancer tissue using CSB-PA826954(IDH1 Antibody) at dilution 1/50, on the right is treated with fusion protein. (Original magnification: ×200)
-
Gel: 8%SDS-PAGE, Lysate: 40 μg, Lane 1-2: 231 cells, hela cells, Primary antibody: CSB-PA826954(IDH1 Antibody) at dilution 1/550, Secondary antibody: Goat anti rabbit IgG at 1/8000 dilution, Exposure time: 20 seconds
-
-
其他:
產品詳情
-
Uniprot No.:
-
基因名:
-
別名:Cytosolic NADP isocitrate dehydrogenase antibody; Cytosolic NADP-isocitrate dehydrogenase antibody; Epididymis luminal protein 216 antibody; Epididymis secretory protein Li 26 antibody; HEL-216 antibody; HEL-S-26 antibody; ICDH antibody; IDCD antibody; IDH antibody; IDH1 antibody; IDHC_HUMAN antibody; IDP antibody; IDPC antibody; Isocitrate dehydrogenase (NADP(+)) 1 cytosolic antibody; Isocitrate dehydrogenase [NADP] cytoplasmic antibody; Isocitrate dehydrogenase 1 (NADP+) soluble antibody; NADP dependent isocitrate dehydrogenase cytosolic antibody; NADP dependent isocitrate dehydrogenase peroxisomal antibody; NADP(+)-specific ICDH antibody; Oxalosuccinate decarboxylase antibody; PICD antibody
-
宿主:Rabbit
-
反應種屬:Human,Mouse,Rat
-
免疫原:Fusion protein of Human IDH1
-
免疫原種屬:Homo sapiens (Human)
-
標記方式:Non-conjugated
-
抗體亞型:IgG
-
純化方式:Antigen affinity purification
-
濃度:It differs from different batches. Please contact us to confirm it.
-
保存緩沖液:-20°C, pH7.4 PBS, 0.05% NaN3, 40% Glycerol
-
產品提供形式:Liquid
-
應用范圍:ELISA,WB,IHC
-
推薦稀釋比:
Application Recommended Dilution ELISA 1:1000-1:5000 WB 1:200-1:1000 IHC 1:50-1:200 -
Protocols:
-
儲存條件:Upon receipt, store at -20°C or -80°C. Avoid repeated freeze.
-
貨期:Basically, we can dispatch the products out in 1-3 working days after receiving your orders. Delivery time maybe differs from different purchasing way or location, please kindly consult your local distributors for specific delivery time.
-
用途:For Research Use Only. Not for use in diagnostic or therapeutic procedures.
相關產品
靶點詳情
-
基因功能參考文獻:
- mutational status of IDH1 in paired primary-recurrent intrahepatic cholangiocarcinoma PMID: 29871612
- High IDH1 expression is associated with Malignant Transformation of Benign Prostatic Epithelium. PMID: 29331887
- Low IDH1 expression level might be an adverse prognostic biomarker for clinical outcomes of ccRCC patients, and two nomograms with IDH1 are potential effective prognostic models for ccRCC. PMID: 30153799
- In this review, we summarize current knowledge regarding the function of normal and mutated IDH(socitrate dehydrogenases 1 and 2 ), explain the possible mechanisms through which these mutations might drive malignant transformation of progenitor cells in the central nervous system, and provide a comprehensive review of potential treatment strategies for IDH-mutated malignancies, focusing on gliomas. PMID: 30194083
- In patients with supratentorial diffuse gliomas, IDH1-R132H mutations are associated with a more severe phenotype of postoperative epilepsy. These findings support further research into IDH mutations, and the potential for an antiepileptic therapeutic effect of their inhibitors, in patients with glioma-associated epilepsy. PMID: 29172136
- Ollier disease is thought to be caused by a post-zygotic mutation of IDH resulting in a mosaicism and IDH mutation is a common genetic event in tumorigenesis. PMID: 30159860
- Identification of driver and subclonal mutations in ASXL1 and IDH1/IDH2 genes in an Argentine series of patients with myelofibrosis. PMID: 29761621
- an overview of the biological and clinical implications of IDH1 and IDH2 mutations in acute myeloid leukemia (review). PMID: 29543066
- genetic association studies in population in Czech Republic: Data suggest that mutations in IDH1 and IDH2 are associated with AML (acute myeloid leukemia); IDH1/2-based monitoring of MRD (minimal residual disease) appears to have prognostic value for residual disease in AML patients. PMID: 30176240
- There was significant prognostic difference among the 4 glioma subtypes. Combined IDH and TERT gene mutation analysis may be useful for prognostic subgrouping. Notably, IDH1 wild-type cases can be further subdivided into TERT(+ ) or (-) subgroups with significant prognostic difference. PMID: 30220117
- Generation of 2-hydroxyglutarate by mutated IDH1/2 leads to the activation of mTOR by inhibiting KDM4A. PMID: 27624942
- IDH1 mutation is associated with glioma progression. PMID: 29016871
- promoter methylation of CTLA4, PD-L1, PD-L2, and PD-1 in diffuse lower-grade gliomas (LGG) harboring isocitrate dehydrogenase (IDH) mutation, is reported. PMID: 29396294
- IDH1 and B7H3 cannot be used as independent prognostic factors, co-expression of IDH1 and B7H3 significantly correlated with the prognosis of CRC patients and may serve as a combined predictive marker. Thus, the correlation between IDH1 and B7H3 has been proven in vivo and in vitro. PMID: 29871819
- Co-administration of VOR did not increase the overall response rate (P = 0.84) or overall survival (OS; P = 0.32). Specifically, no benefit was identified in either de novo or relapsed AML. Mutations in the genes CDKN2A (P = 0.0001), IDH1 (P = 0.004), and TP53 (P = 0.003) were associated with reduced OS PMID: 28765326
- IDH mutant gliomas are less aggressive, occur in younger patients, are easier to resect, more chemosensitive, and associated with longer survival when compared with IDH wild-type tumors, regardless of histologic grade. PMID: 29369751
- IDH1 gene mutation is exclusive in supratentorial Brain Tumors and more frequent in secondary ones, with a greater survival trend and better progression free survival in patients who carry it. PMID: 28948065
- we elucidated the antitumor effect of curcumol on MGC-803 cells and the involved mechanisms related to the induction of apoptosis, the increase of ROS, the decrease of MMP and the downregulation of IDH1. PMID: 29039582
- Study provides the first evidence that ID1 conferred oxaliplatin resistance in hepatocellular carcinoma proliferation by activating the pentose phosphate pathway. PMID: 29169374
- No correlation between IDH1/2 mutation status and sensitivity for NAMPT inhibitors was observed. Strikingly, higher methylation of the NAPRT promoter was observed in high-grade versus low-grade chondrosarcomas. In conclusion, this study identified NAMPT as a potential target for treatment of chondrosarcoma PMID: 28860121
- IDH1 mutation, karyotype risk and the revised International Prognostic Scoring System risk category were independent inferior prognostic factors. PMID: 28873367
- Results highlight that non-canonical IDH mutations are relatively common in grade II and III gliomas: it is therefore important to analyze exon 4 of both IDH1 and IDH2 in these tumors. They also demonstrate that all IDH mutations, including the non-canonical ones are clonally distributed, a finding consistent with their driver role in gliomagenesis. PMID: 28748342
- IDH1 mutation promotes gliomagenesis not by altering cell growth but by arresting differentiation of Neural Stem Cells, which become locked in a self-renewing and brain-invasive state. PMID: 29091765
- Data demonstrate that IDH1 mutation reduces the malignant progression of glioma by causing a less aggressive phenotype of GSCs which are involved in the Wnt/betacatenin signaling. PMID: 29115585
- Results demonstrated that wild-type IDH1 is over-expressed in lung adenocarcinoma which probably promoted tumor progression via increasing cancer stem cells survival. PMID: 29537891
- Low expression of IDH1 is associated with osteosarcoma. PMID: 28534992
- Patients with grade II gliomas showed a higher rate of IDH1 and IDH2 mutations and seizures than patients with grade III and IV gliomas--{REVIEW} PMID: 29288860
- current meta-analysis identified that IDH1 mutation was correlated to a higher preoperative seizure incidence in low-grade gliomas PMID: 29414139
- inhibition of Bcl-xL induces significantly more apoptosis in IDH1-mutated cells than in wild-type IDH1 cells. PMID: 29057925
- The rare occurrence of IDH1 mutant high-grade thalamic gliomas strongly suggested that the high-grade thalamic glioma is another distinct tumor entity as compared to the high-grade superficial gliomas. PMID: 28869450
- Our findings indicate that IDH1WT glioma have a typical Warburg phenotype whereas in IDH1MUT glioma the TCA cycle, rather than glycolytic lactate production, is the predominant metabolic pathway. Our data further suggest that the TCA in IDH1MUT glioma is driven by lactate and glutamate anaplerosis to facilitate production of alpha-KG, and ultimately D-2-HG. PMID: 28467784
- The aim of this study is to determine the prevalence of IDH mutations and EGFR amplifications in the population of the northeast region of Morocco and then to compare the results with other studies. PMID: 28785587
- this epigenetic antagonism precedes malignant transformation and can be observed in preleukemic LSK cells from Idh2(R140Q) or Dnmt3a(R882H) single-mutant and Idh2(R140Q)/Dnmt3a(R882H) double-mutant mice. IDH/DNMT3A double-mutant acute myeloid leukemia (AML)manifested upregulation of a RAS signaling signature and displayed unique sensitivity to MEK inhibition ex vivo as compared with AMLs with either single mutation. PMID: 28408400
- IDH1(R314C) lacks isocitrate-to-alpha-ketoglutarate conversion activity due to reduced affinity for NADP(+), and differs from the IDH1(R132) mutants in that it does not produce D-2-hydroxyglutarate. PMID: 27460417
- Findings demonstrated that miR-148a promotes glioma cell invasion and tumorigenesis by downregulating GADD45A. Findings provide novel insights into how GADD45A is downregulated by miR-148a in IDH1R132H glioma PMID: 28445981
- Glioblastoma multiforme HIF1-alpha and serum VEGF levels were found to be significantly increased in IDH1-mutated tumor tissues.Mutated IDH1 may contribute to carcinogenesis via induction of HIF-1 alpha pathway in primary glioblastoma multiforme. PMID: 28667042
- IDH1 mutation is associated with 1p19q co-deletion diffuse glioma. PMID: 28340142
- DNA mutational analysis in IDH1 in acute myeloid leukemia. PMID: 27071442
- Authors conclude that PROX1 is a new prognostic biomarker for 1p19q non-codeleted high-grade astrocytomas that have progressed from pre-existing low-grade tumors and harbor IDH1 mutations. PMID: 27626492
- In primary human acute myeloid leukemia samples, the 2-hydroxyglutarate levels observed in samples with mutant IDH1 or IDH2 status were higher than those observed in samples without an enzyme mutation, similar to what was observed in the original study (Figure 5C; Ward et al., 2010). PMID: 28653623
- Results present a unique phenotype of isocitrate dehydrogenase-mutation primary de novo glioblastomas arising from insular cortex region, the molecular backgrounds of which are similar to secondary glioblastomas. PMID: 28116838
- These findings suggest that IDH1 upregulation represents a common metabolic adaptation by glioblastoma to support macromolecular synthesis, aggressive growth, and therapy resistance. PMID: 28564604
- Patients with low IDH1-R132H expression had a poor overall survival. Our data indicate that IDH1-R132H expression could be used as a predictive marker of prognosis for patients with gastrointestinal cancer. PMID: 27655638
- ATRX deficiency was mutually exclusive with LOH. Conversely, ATRX-proficient tumours immunoreactive for R132H-mutant isocitrate dehydrogenase 1 (IDH1) showed a high rate (85%) of LOH. PMID: 26016385
- FZD7 and IDH1 were assessed by immunohistochemistry in tissue microarrays. PMID: 27409829
- TET2, ASXL1, IDH1, and IDH2 Single Nucleotide Polymorphisms in Turkish Patients with Chronic Myeloproliferative Neoplasms. PMID: 28218607
- our finding that the expression of MCT1 and MCT4 is reduced in mutant IDH1 gliomas highlights the unusual metabolic reprogramming that occurs in mutant IDH1 tumors and has important implications for our understanding of these tumors and their treatment PMID: 27144334
- IDH1/2 mutations induce a homologous recombination defect that renders tumor cells exquisitely sensitive to poly(adenosine 5'-diphosphate-ribose) polymerase inhibitors PMID: 28148839
- To confirm this result, we analyzed survival data from 142 LGGs from TCGA with IDH1/IDH2 mutations and no 1p19q codeletion. Despite the high rate of censured data, we found that CNLOH 17p, including the TP53 locus, was associated with better outcome (OR = 0.27; p = .026) PMID: 27401888
- Results suggest that to better treat gliomas, isocitrate dehydrogenase (NADP(+)) 1 (IDH-1) mutation status should be included when determining WHO2007 grade in glioma patients. PMID: 27120786
顯示更多
收起更多
-
相關疾病:Glioma (GLM)
-
亞細胞定位:Cytoplasm, cytosol. Peroxisome.
-
蛋白家族:Isocitrate and isopropylmalate dehydrogenases family
-
數據庫鏈接:
Most popular with customers
-
-
Phospho-YAP1 (S127) Recombinant Monoclonal Antibody
Applications: ELISA, WB, IHC
Species Reactivity: Human
-
-
-
-
-
-